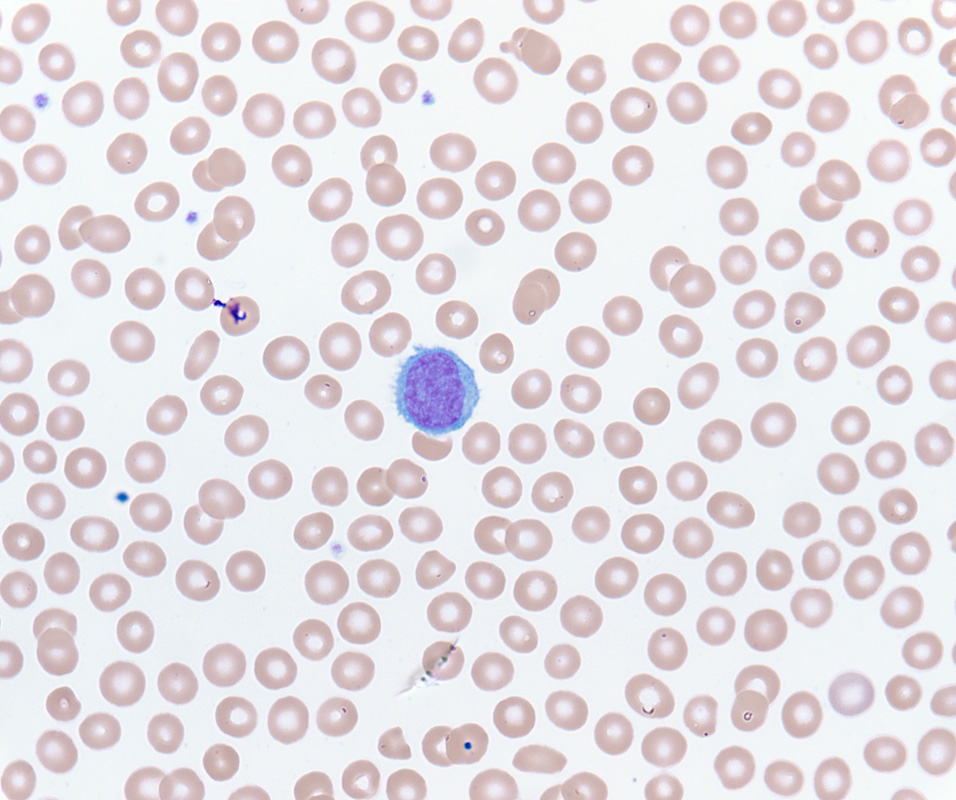

Case History
A 58-year-old man presented with lymphocytosis, splenomegaly, and thrombocytopenia. Based on the provided blood smear, bone marrow biopsy, and bone marrow flow cytometry, which of the following is most likely?
- Hairy cell leukemia
- Multiple myeloma
- Acute lymphocytic leukemia
- Splenic marginal zone lymphoma
Answer: D. Splenic marginal zone lymphoma
The correct answer is splenic marginal zone lymphoma. The presence of circulating lymphoma cells with villous projections in the peripheral blood of a patient with splenomegaly should immediately raise suspicion for either splenic marginal zone lymphoma or hairy cell leukemia. Since both of these entities are negative for CD5 and CD10, they may also appear similar on initial immunohistochemical or flow cytometric workup. However, several key differences in morphology and immunophenotype help to differentiate these two neoplasms.
In the peripheral blood, the cytoplasmic projections seen in circulating splenic marginal zone lymphoma cells are classically polarized to either end of the cell, in contrast to the circumferential projections common in hairy cell leukemia. In the bone marrow, splenic marginal zone lymphoma may be present as interstitial, paratrabecular, or intrasinusoidal infiltrates. Hairy cell leukemia involving the bone marrow is characterized by perinuclear halos that impart a “fried egg” appearance on histology and by unsuccessful bone marrow aspirates due to fibrosis. For the purposes of this question, these morphologic differences are key to choosing the correct answer.
In practice, however, immunophenotypic confirmation (whether by flow cytometry or immunohistochemistry) is required to distinguish splenic marginal zone lymphoma from hairy cell leukemia. As mentioned above, both are negative for CD5, CD10, and many other markers common in the initial workup of small B cell lymphomas. Hairy cell leukemia is typically positive for CD11c, CD103, CD25, and annexin A1. While splenic marginal zone lymphoma may sometimes show expression of some of these antigens, the strong co-expression of these markers almost always indicates hairy cell leukemia. If available, molecular findings, specifically the BRAF V600E mutation, are also indicative of hairy cell leukemia. This particular case was negative for CD11c and CD25 with dim expression of CD11c.
Case contributed by: David Dorn, M.D.